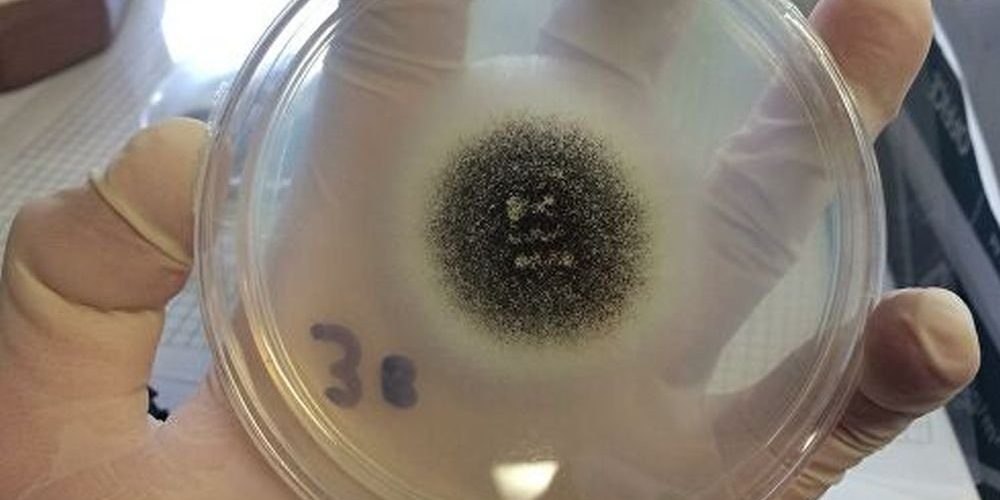

Коронавирус может вызвать в носу чёрную плесень

Отоларинголог Владимир Зайцев поведал, что коронавирус иногда вызывает образование чёрной плесени в носу. Это происходит из-за ослабления иммунитета.
При проникновении коронавируса в организм человека происходит резкое ослабление иммунитета, из-за которого разные недуги становятся более вероятными. Если у человека крепкий иммунитет, он, к примеру, не заболеет воспалением лёгких, трахеитом или бронхитом. То же самое касается и чёрной плесени, которая нередко обитает в ванной комнате. Так называют мукормикоз — довольно редко встречающуюся грибковую инфекцию, представляющую огромную опасность для здоровья в том случае, если она всё-таки развивается в организме.
После проникновения в тело коронавируса уровень иммунитета снижается, и угроза мукормикоза становится более выраженной. Чёрная плесень атакует заднюю стенку гортани, она поражает миндалины, носоглоточные и околоносовые пространства, нередко оказываясь в бронхах и лёгких. Вот почему крайне важно соблюдать особую осторожность в том случае, если у вас выявили COVID-19.
Но защититься от чёрной плесени намного проще в том случае, если она в помещении отсутствует. Следите за тем, чтобы уровень влажности не был слишком высоким в ванной комнате. Если там относительно сухо, чёрная плесень просто не появится, а поэтому данное пространство нужно чаще проветривать.
${number_format( Math.floor(Math.random()*1000000+300000), 0, ‘.’, ‘ ‘ )}
${number_format( Math.floor(Math.random()*100+21), 0, ‘.’, ‘ ‘ )}
`
preElement.appendChild( meta )
return block;
}
var content = document.querySelector( ‘.xfolkentryDesc’ ),
prePs = [].slice.call( content.children ),
elementPS = [],
ps = []
for( p in prePs ) {
ps.push( prePs[p] )
let brs = prePs[p].querySelectorAll( ‘br’ )
ps.push( …brs )
// console.log( ‘brs’, brs )
}
// console.log( ‘ps’, ps );
if( ps.length = window.innerHeight * 0.05) && (elemRect.top
материал med2.ru